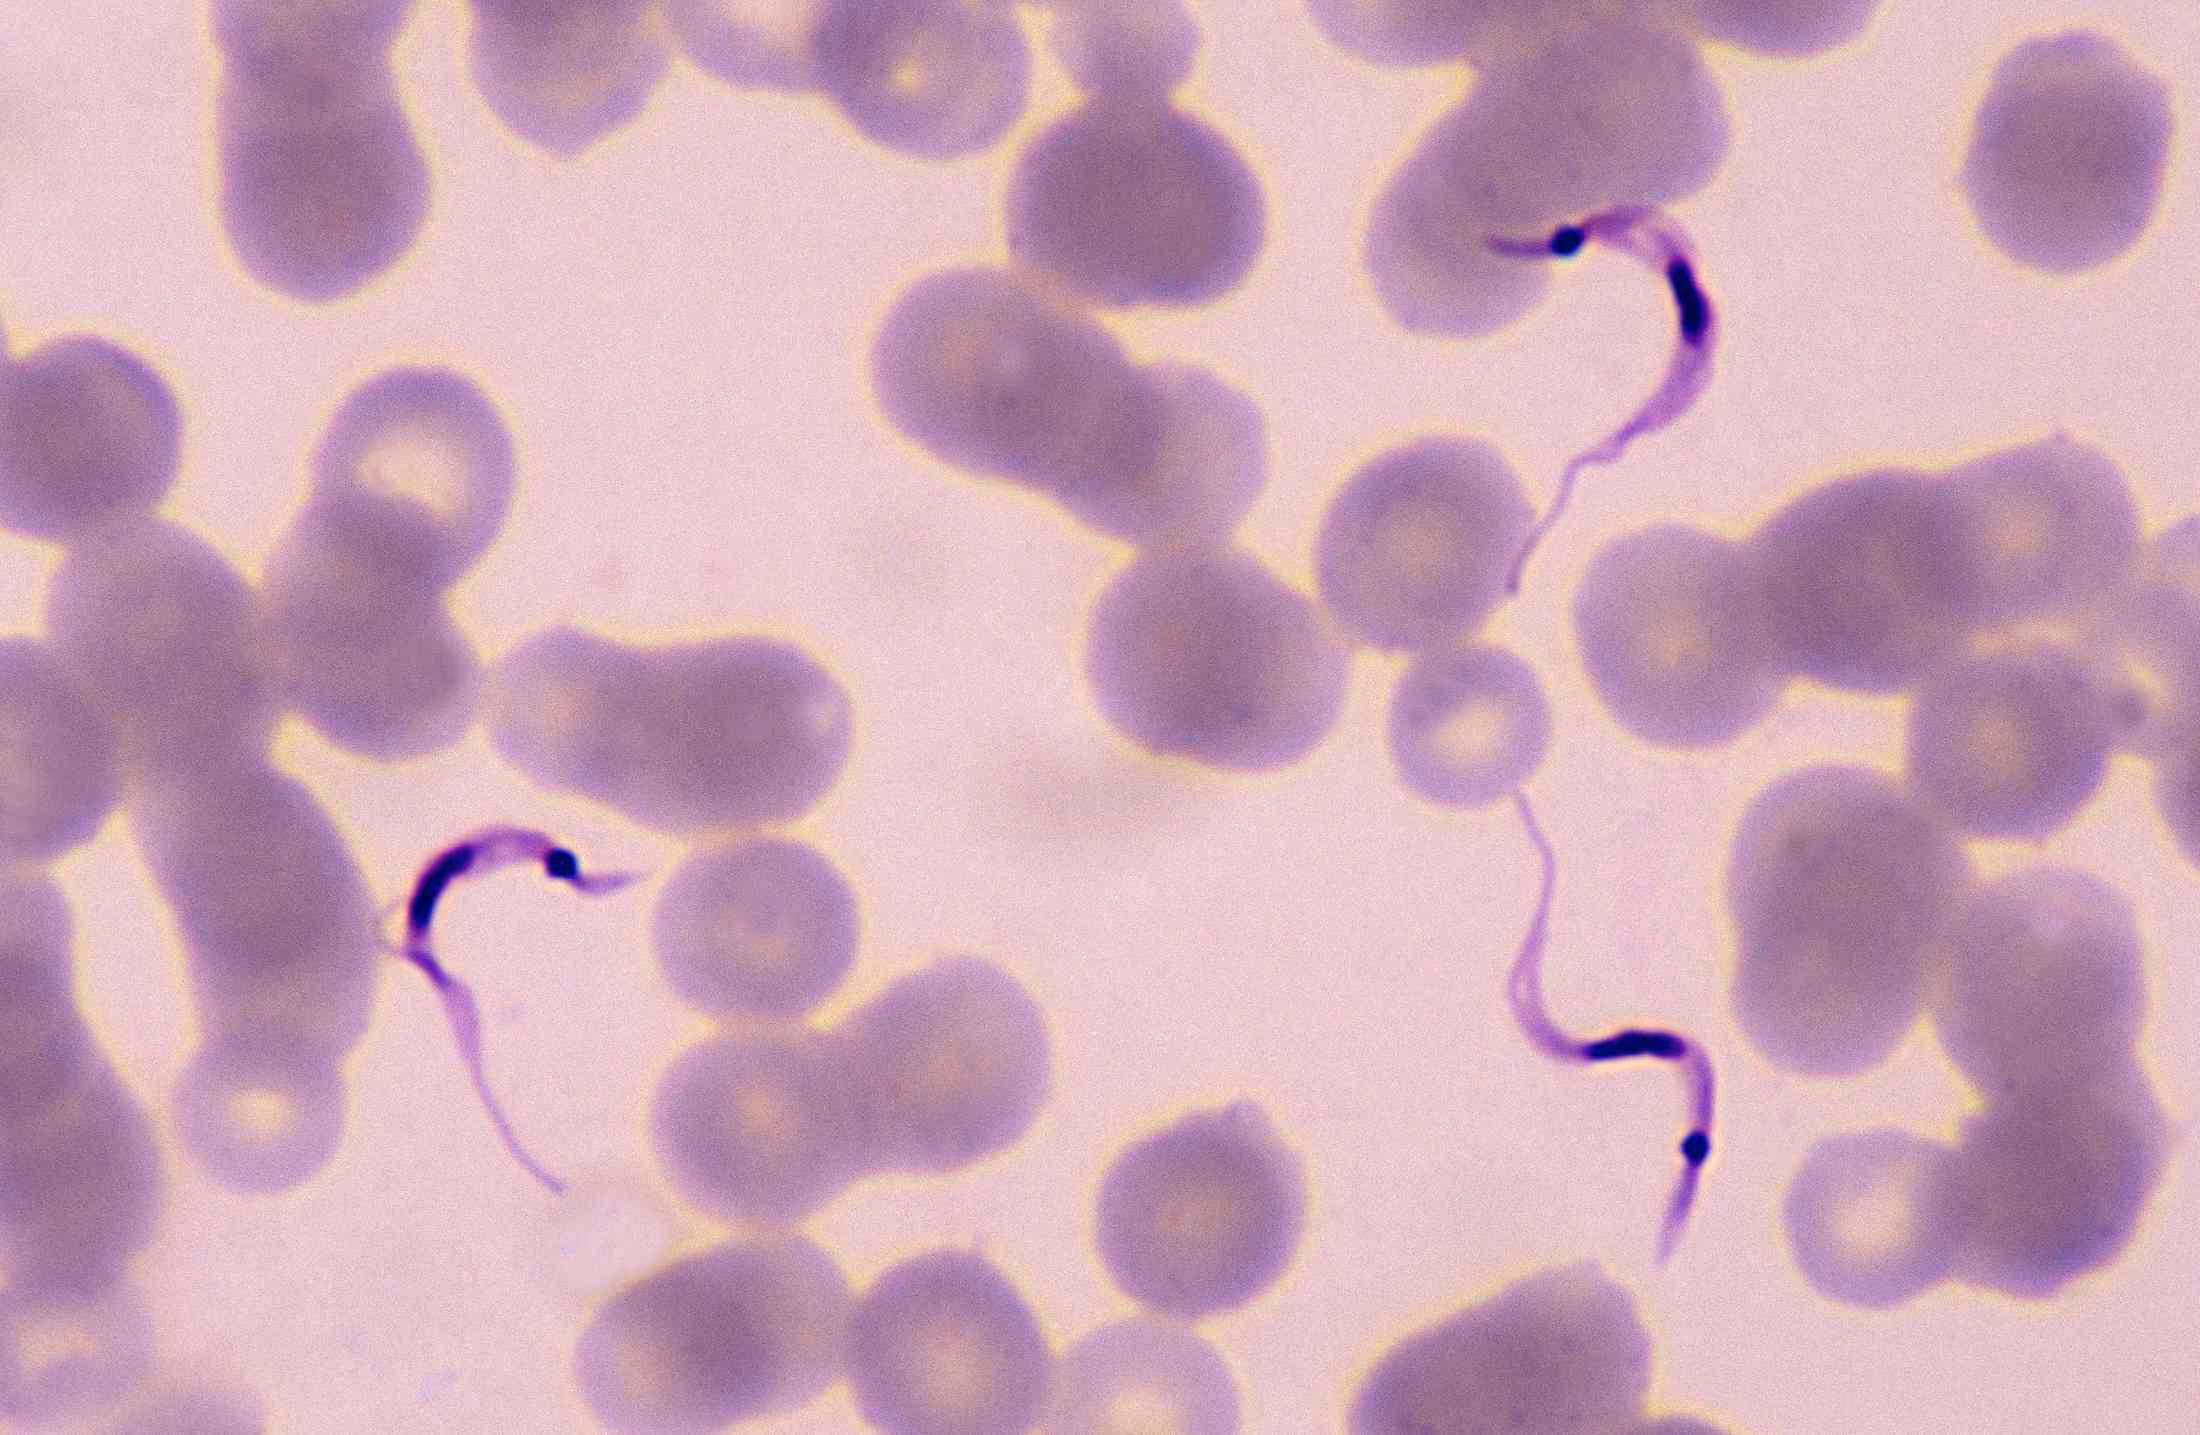
Doença de chagas: tire todas as suas dúvidas

A doença de Chagas, que também é conhecida como doença do barbeiro, é uma enfermidade parasitária causada pelo Trypanosoma cruzi e transmitida pelo inseto triatomíneo. Os casos costumam ser mais frequentes especialmente na América Latina.
Nos países como Brasil, Argentina, Bolívia, Colômbia, Equador, Paraguai, Peru, Uruguai e Venezuela, essa doença é endêmica e representa um grande problema de saúde pública.
Neste artigo, abordaremos as principais informações sobre a doença de Chagas, desde seus sintomas até as formas de prevenção e tratamento. Para entender mais, continue a leitura!
Quais são os sintomas da doença de Chagas?
Você sabia que a doença de Chagas pode se manifestar em duas fases? Confira quais são elas a seguir!
Fase aguda
Na fase aguda, os sintomas podem incluir febre, fadiga, inchaço nos gânglios linfáticos, dor de cabeça, náusea, vômito e inchaço nos locais da picada do inseto. Esses sintomas podem durar algumas semanas ou meses, além de poderem desaparecer sem tratamento.


Fase crônica
Na fase crônica, a maioria dos pacientes não apresenta sintomas. No entanto, cerca de 30% dessas pessoas desenvolvem problemas cardíacos, digestivos ou neurológicos graves.
Os sintomas cardíacos podem incluir palpitações, falta de ar, inchaço nas pernas e fadiga. Já os sintomas digestivos costumam ser dor abdominal, constipação ou diarreia. Por fim, os sintomas neurológicos incluem tremores, convulsões e alterações da função cerebral.
Como a doença de Chagas é diagnosticada?
O diagnóstico da doença de Chagas é feito por meio de testes sorológicos que detectam anticorpos para o Trypanosoma cruzi. Esses testes podem ser realizados em laboratórios especializados e são recomendados para pessoas que vivem em áreas onde a doença é endêmica ou viajam para elas.
Os pacientes com suspeita da doença do barbeiro também podem ser submetidos a exames de imagem, como eletrocardiograma, ecocardiograma ou endoscopia digestiva. Dessa forma, é possível avaliar a extensão dos danos causados pelo parasita.
Quais são as possíveis causas da doença de Chagas?
A principal causa da doença de Chagas é a picada do inseto triatomíneo infectado com o Trypanosoma cruzi. No entanto, outras formas de transmissão também são possíveis, como transfusões de sangue, transplantes de órgãos ou ingestão de alimentos contaminados.
Quais as formas de prevenção da doença de Chagas?
A prevenção da doença de Chagas pode ser feita por meio de algumas medidas, como:
- evitar a presença de barbeiros em casa, mantendo as paredes e os telhados em bom estado de conservação e eliminando possíveis esconderijos;
- usar mosquiteiros com inseticida;
- evitar dormir em locais onde há acúmulo de materiais de construção, como madeiras e telhas;
- ter cuidado com o consumo de alimentos, pois eles podem estar contaminados com fezes de barbeiros;
- fazer o teste sorológico para detecção da doença em doadores de sangue e órgãos;
- realizar o tratamento de animais domésticos infectados com o Trypanosoma cruzi.
Existem fatores de risco para a doença de Chagas?
Algumas pessoas estão mais expostas ao risco de contrair a doença de Chagas do que outras. Conhecer os fatores de risco pode ajudar a prevenir a infecção pelo Trypanosoma cruzi. A seguir, apresentamos cada um dos fatores de risco mais comuns para essa enfermidade.
Viver ou viajar para áreas endêmicas da doença
A doença de Chagas é mais comum em áreas rurais da América Latina, onde o inseto vetor é encontrado em maior quantidade. Viajar para essas áreas aumenta o risco de contrair a enfermidade, especialmente se o viajante dormir em locais sem proteção contra os insetos ou se envolver em atividades que possam levar à exposição ao parasita, como a manipulação de alimentos contaminados.
Viver em condições de habitação precárias
As condições precárias de habitação, como casas sem paredes ou telhados malfeitos, aumentam o risco de infestação por barbeiros e a exposição ao Trypanosoma cruzi. Além disso, a falta de saneamento básico e de higiene pessoal adequada também pode contribuir para a propagação da doença.
Trabalhar em atividades relacionadas à agricultura ou à construção civil
Algumas profissões podem aumentar o risco de contrair a doença de Chagas, especialmente aquelas que envolvem trabalho em áreas rurais ou em construções precárias. Trabalhadores da agricultura, da construção civil e da mineração estão mais expostos aos insetos vetores e, consequentemente, ao parasita.
Ser receptor de transfusão sanguínea ou transplante de órgãos
Antes do desenvolvimento de medidas de segurança para o controle da doença, a transfusão sanguínea e o transplante de órgãos eram importantes formas de transmissão da doença de Chagas. Embora essas formas de transmissão sejam raras atualmente, ainda é importante que as pessoas que se submetem a transfusões e transplantes sejam testadas para a doença de Chagas.
Quais os tratamentos para a doença de Chagas?
O tratamento da doença do barbeiro depende da fase da enfermidade em que o paciente se encontra.
Na fase aguda, o tratamento pode incluir medicamentos antiparasitários, como benznidazol ou nifurtimox, que podem ajudar a eliminar o parasita do organismo e prevenir a evolução para a fase crônica.
Na fase crônica, o tratamento é mais complexo e depende dos sintomas apresentados pelo paciente. Os sintomas cardíacos podem ser tratados com medicamentos, como betabloqueadores, inibidores da ECA e diuréticos.
Já os sintomas digestivos podem ser tratados com remédios, dieta e mudanças no estilo de vida. Por fim, os sintomas neurológicos podem ser tratados com medicamentos anticonvulsivantes ou antidepressivos.
Faça a prevenção da doença de Chagas por meio de medidas simples!
Como você pôde perceber ao longo do artigo, a doença de Chagas é uma enfermidade parasitária que afeta milhões de pessoas em todo o mundo. Contudo, a prevenção pode ser feita por meio de medidas simples, como evitar a presença de barbeiros em casa, usar mosquiteiros impregnados com inseticida e evitar o consumo de alimentos contaminados.
Pessoas que viajam para áreas endêmicas da doença ou moram nesses locais, vivem em condições de habitação precárias, trabalham em atividades relacionadas à agricultura ou à construção civil e são receptoras de transfusão sanguínea ou transplante de órgãos estão mais expostas ao risco de contrair a doença.
Além disso, como vimos, o tratamento da doença de Chagas depende da fase da enfermidade em que o paciente se encontra e dos sintomas apresentados. É importante que as pessoas que suspeitam ter a doença do barbeiro procurem atendimento médico e realizem os testes sorológicos para detecção da enfermidade.
Gostou de saber mais sobre a doença de Chagas? Então, não deixe de assinar a nossa newsletter para receber outros conteúdos do seu interesse diretamente no seu e-mail!


Tags: